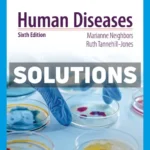
Human Diseases 6th Edition Neighbor Solutions Manual

HR 6th Edition DeNisi Test Bank
$65.00 Original price was: $65.00.$31.00Current price is: $31.00.
Unlock comprehensive preparation with the HR 6th Edition DeNisi Test Bank, an essential resource designed to enhance your understanding of human resource management concepts. This test bank is perfect for students, educators, and professionals looking to excel in exams and assessments.
Gain access to a complete collection of expertly crafted questions and their correct answers, tailored to the HR 6th Edition by DeNisi. Whether you’re studying for an upcoming test or aiming to broaden your subject knowledge, this test bank is your dependable study companion.
Delivered as an instant download, the test bank ensures you can begin your study session without delay. Obtained directly from authentic publishers, it includes all chapters of the HR 6th Edition, offering a reliable and thorough preparation tool.
Maximize Your Exam Potential with the Right Resources
Utilizing the HR 6th Edition DeNisi Test Bank can significantly boost your exam performance and conceptual understanding by providing:
– A comprehensive set of test questions with correct answers aligned with the textbook.
– An organized structure that mirrors the HR 6th Edition textbook, making it easy to follow and use.
– Instant access to all chapters, allowing for flexible, on-demand study sessions.
– Authentic content obtained directly from publishers, ensuring reliability and accuracy.
– A powerful tool for educators crafting tests and quizzes, saving time and ensuring alignment with the curriculum.
Using this test bank not only prepares you for success but also deepens your understanding of human resource management’s core principles and practices. Begin your journey toward academic excellence today with our instant download options.


Reviews
There are no reviews yet.